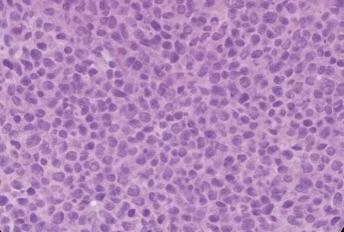
Figure 2

1. Introduction
Lambert–Eaton myasthenic syndrome (LEMS) is a rare autoimmune disorder of the presynaptic neuromuscular junction, characterized by impaired acetylcholine release due to autoantibodies targeting P/Q-type voltage-gated calcium channels (VGCCs).1 Clinically, LEMS commonly presents with symmetrical proximal muscle weakness, reduced or absent deep tendon reflexes, and autonomic disturbances including dry mouth, constipation, and orthostatic hypotension.2 Although LEMS may occur idiopathically, approximately 50–70% of adult cases are paraneoplastic, most frequently associated with small-cell lung carcinoma (SCLC).3 In paraneoplastic cases, neuromuscular symptoms often precede the diagnosis of the underlying malignancy, making LEMS an important early clinical indicator of occult cancer.4
The diagnosis of LEMS relies on a combination of clinical evaluation, electrophysiological studies, and serological testing for anti-VGCC antibodies. Electromyography typically reveals low-amplitude compound muscle action potentials (CMAPs) with incremental response to high-frequency repetitive nerve stimulation, a hallmark of presynaptic neuromuscular junction dysfunction.5 Elevated anti-P/Q-type VGCC antibodies support the autoimmune pathogenesis of LEMS.6 Imaging studies, including chest computed tomography (CT) and positron emission tomography–CT (PET-CT), are essential for detecting occult malignancy, most commonly SCLC.7 Immunohistochemical staining revealed extensive expression of P/Q-type VGCC in the cancer cells, which supports a tumor-associated mechanism.8
Early recognition of paraneoplastic LEMS is clinically significant, as prompt treatment of the underlying malignancy often leads to substantial improvement in neuromuscular symptoms.9 Previous studies have documented cases in which neuromuscular improvement occurred following tumor-directed therapy, underscoring the importance of an integrated diagnostic approach.10 Here, we present a detailed case of paraneoplastic LEMS that unveiled previously undiagnosed small-cell lung carcinoma (SCLC), highlighting diagnostic strategies, clinical course, and management considerations.
2. Case Presentation
A 68-year-old male with a 40-pack-year smoking history presented with a six-month history of progressive proximal muscle weakness affecting the lower limbs, difficulty climbing stairs, and frequent falls. He also reported dry mouth, mild constipation, and episodic dizziness on standing. There was no history of sensory deficits, cranial nerve involvement, or prior neuromuscular disorders. The patient had no prior history of autoimmune disease, neuromuscular disorders, malignancy, or chronic systemic illness. He reported no family history of neuromuscular disorders, autoimmune disease, or lung cancer. He was not taking any chronic medications and denied recent exposure to drugs known to impair neuromuscular transmission. He denied alcohol or illicit drug use.
On presentation, vital signs were as follows: temperature 36.8 °C, heart rate 78 beats per minute, respiratory rate 16 breaths per minute, and oxygen saturation 97% on room air. Blood pressure was 138/82 mmHg in the supine position, with a decrease to 113/70 mmHg upon standing, consistent with orthostatic hypotension. Neurological examination revealed symmetrical proximal muscle weakness, graded 3/5 in the lower limbs and 4/5 in the upper limbs according to the Medical Research Council (MRC) scale, with relative preservation of distal muscle strength. Deep tendon reflexes were absent in the lower extremities and reduced in the upper extremities, with facilitation noted after brief muscle activation. Sensory examination was normal, including light touch, pinprick, vibration, and proprioception. Cranial nerve examination was unremarkable, and no cerebellar signs or pathological reflexes were observed.
Laboratory tests were unremarkable: hemoglobin 13.2 g/dL, WBC 6.8 ×10³/µL, platelets 220 ×10³/µL, fasting glucose 95 mg/dL, creatinine 0.9 mg/dL, and electrolytes within normal limits. Anti–P/Q-type VGCC antibodies were elevated at 120 pmol/L (reference <20 pmol/L). Nerve conduction studies demonstrated low-amplitude CMAPs in the proximal muscles, with >100% increment following 20 Hz repetitive stimulation, consistent with presynaptic neuromuscular junction disorder (Table 1), low baseline CMAP amplitudes with marked facilitation (>100%) on high-frequency repetitive nerve stimulation indicated a presynaptic neuromuscular junction disorder, supporting the diagnosis of Lambert–Eaton myasthenic syndrome and prompting evaluation for an underlying malignancy.
Chest CT revealed a 3 cm left apical pulmonary mass with no apparent lymphadenopathy (Figure 1). The identification of a hypermetabolic left apical lung mass provided a likely source of paraneoplastic antibody production and guided definitive surgical management. PET-CT demonstrated hypermetabolic activity corresponding to the mass (SUVmax 9.5). No distant metastases were identified. The patient underwent left upper lobectomy. Histopathological examination showed sheets of small, round blue cells with high nuclear-to-cytoplasmic ratio, finely granular chromatin, nuclear molding, and numerous mitotic figures, consistent with small-cell lung carcinoma (Figure 2). Immunohistochemistry was positive for synaptophysin, chromogranin, and P/Q-type VGCCs, confirming the paraneoplastic etiology of LEMS.
Postoperatively, the patient received adjuvant platinum-etoposide chemotherapy. Neurological symptoms improved progressively over 3–6 months: proximal muscle strength in lower limbs improved to 4/5, deep tendon reflexes partially returned, and autonomic symptoms resolved. Follow-up electrophysiology showed normalization of CMAP facilitation. At 12 months, the patient remained in remission with stable muscle strength and no recurrence of SCLC.
3. Discussion
Paraneoplastic LEMS is an important clinical syndrome, often serving as the first manifestation of SCLC. The pathophysiology involves autoantibodies against presynaptic VGCCs, leading to impaired calcium influx and reduced acetylcholine release at the neuromuscular junction.11 Clinical features include symmetric proximal muscle weakness, absent or diminished reflexes, and autonomic dysfunction. In approximately 60% of paraneoplastic cases, neuromuscular symptoms precede the cancer diagnosis by months, as in our patient.12
Electrophysiological studies, including repetitive nerve stimulation, are highly sensitive for presynaptic neuromuscular transmission defects, with a >100% increment on high-frequency stimulation considered diagnostic.13 Serological testing for anti-P/Q-type VGCC antibodies further supports the autoimmune mechanism.14 These combined diagnostic modalities allow early identification of paraneoplastic LEMS and guide cancer surveillance.
The differential diagnosis of proximal muscle weakness with fatigability includes myasthenia gravis (MG), inflammatory myopathies, motor neuron disease, and metabolic or endocrine myopathies.15 MG, the main diagnostic consideration, differs from LEMS in key aspects. MG is a postsynaptic neuromuscular junction disorder typically presenting with fluctuating weakness, ocular or bulbar involvement, and preserved reflexes, whereas LEMS is characterized by symmetrical proximal weakness, hyporeflexia or areflexia, and autonomic dysfunction.16 Electrophysiologically, MG shows a decremental response on low-frequency repetitive nerve stimulation, in contrast to the marked incremental CMAP facilitation seen in LEMS.17 The presence of elevated anti–P/Q-type VGCC antibodies further supports a presynaptic etiology.18
Other causes of proximal weakness were considered unlikely due to normal laboratory findings, absence of sensory or upper motor neuron signs, and characteristic electrophysiological features, supporting the diagnosis of paraneoplastic Lambert–Eaton myasthenic syndrome.19 SCLC is the malignancy most frequently associated with LEMS, accounting for up to 50–70% of cases.20
Tumor resection and systemic chemotherapy often lead to an improvement in neuromuscular symptoms due to reduction in autoantibody production.21 In our patient, surgical excision of the primary tumor, followed by chemoradiotherapy, has been documented to enhance symptoms of LEMS, such as muscle weakness, reflexes, and autonomic function.22 Strengths of this case include comprehensive diagnostic evaluation combining clinical, electrophysiological, serological, imaging, and histopathological findings, providing strong evidence of paraneoplastic LEMS. Furthermore, early tumor-directed therapy demonstrated functional recovery, reinforcing the clinical benefit of timely diagnosis.
Limitations include the lack of long-term antibody titer monitoring and follow-up beyond 12 months, which may have provided additional insight into disease recurrence or persistence of subclinical LEMS symptoms. This case highlights the importance of maintaining high suspicion for LEMS in older adults with unexplained proximal weakness, as early detection may uncover occult malignancy and improve outcomes.
4. Conclusion
Paraneoplastic LEMS may serve as an early indicator of occult SCLC, particularly in older adults with proximal muscle weakness, fatigability, and autonomic features. Prompt diagnosis relies on combined clinical, electrophysiological, and serological assessment, supported by imaging and histopathology. Tumor-directed therapy can lead to significant improvement in neuromuscular function and quality of life. This case underscores the importance of recognizing LEMS as a paraneoplastic syndrome. It emphasises the necessity for clinicians to have a high index of suspicion for occult malignancy in older patients presenting with unexplained proximal muscle weakness and highlights the role of early intervention. Collectively, integrated multimodal evaluation is essential for timely diagnosis and optimal patient outcomes.
Ethics approval
Written informed consent was obtained from the patient for publication of this case report.
Availability of data
Data sharing is not applicable as no new data were generated or analyzed.
Competing interests
The authors declare no competing interests.
Funding
This research received no specific grant from any funding agency in the public, commercial, or not-for-profit sectors.
Authors’ contributions
AR drafted the initial manuscript. NA conceived the study and supervised manuscript preparation. OB, HA, THF, and LAQ contributed to data collection and literature review. All authors revised the manuscript and approved the final version.
Acknowledgements
None.

__suggestive_of_small-cell_lung_carcinoma.jpg)